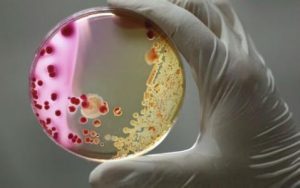

| 폴리우레탄 플라스틱을 분해하는 튜빙겐시스 진균 발견 | ||
|
||
![]() 최근, 중국과학원 쿤밍(昆明)식물연구소 쉬젠추(許建初) 연구팀은 최초로 폴리우레탄(PU) 플라스틱을 효율적으로 분해할 수 있는 진균을 발견함으로써 플라스틱 생분해 영역에서 획기적인 성과를 거두었다. 플라스틱은 생활품질을 향상시키는 동시에 환경을 오염시키는 주요 오염원이기도 하다. 플라스틱 생분해는 글로벌 환경오염 연구의 핫이슈이자 어려운 문제점이다. 플라스틱 폐기물은 수로를 차단시키고 토양을 오염시키며 유해물질을 방출할 뿐만 아니라 심지어 동물에게도 위협을 주고 있다. 1990년대부터 전 세계 과학자들은 플라스틱 생분해 연구를 시작하여 선후로 수십 종 플라스틱 분해 능력을 보유한 진균을 발견하였으나 그 분해 효율이 낮고 분해가 철저하지 못하여 효과를 이상적이지 못하다. 최근, 쉬젠추 연구팀은 쓰레기매립장 토양에서 플라스틱을 “먹을 수 있는” 토양 소형 진균을 분리하였다. 해당 진균은 플라스틱 표면에서 생장하며, 또한 생장과정에서 생성된 효소와 플라스틱의 생물반응을 통하여 플라스틱 분자 사이 혹은 폴리머 사이의 화학결합을 파괴시킨다. 연구팀은 해당 진균을 튜빙겐시스(Aspergillus tubingensis)로 감정하고 명명하였다. 튜빙겐시스 작용조건에서 2주일이면 플라스틱이 생분해되고 2개월 후에는 그 배양기 위의 플라스틱 폴리머가 기본적으로 소실되었다. 해당 성과는 토양오염 처리 및 생태복원에 새로운 단서를 제공하였을 뿐만 아니라, 플라스틱 폐기물 처리를 위해 쓰레기 매립지에 생분해 진균제를 뿌려 쓰레기 더미에서 플라스틱 폴리머의 분해속도와 효율을 크게 가속화 할 수 있는 등 새로운 방법을 제공하였다. 정보출처 : http://news.sciencenet.cn/htmlnews/2017/4/372853.shtm |